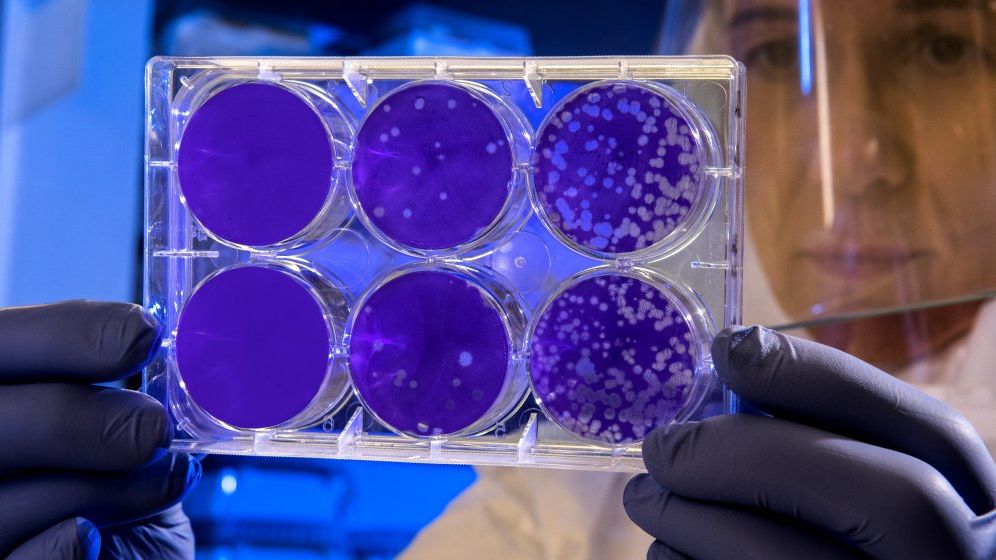
Tot ce se stie pana acum despre coronavirus: in China sunt 41 de morti si 1.300 de persoane contaminate

Contabilizand deja 1,8 miliarde lucratori, regiunea risca sa nu mai poata crea un numar suficient de slujbe pentru a controla saracia economica si informationala extrem de raspandita, precizeaza institutul, potrivit NewsIn.
"Mai este mult de facut" pentru a ameliora calitatea slujbelor create si pentru a asigura, pentru viitor, o mai buna repartitie a beneficiilor cresterii economice in regiune, reiese din acest raport, intitulat "Visions for Asia's Decent Work Decade : Sustainable Growthand Jobs to 2015" (Perspective pentru un deceniu de conditii decente de lucru in Asia: Dezvoltare durabila si locuri de munca pana in 2015).
"Un lucru este sigur-mentinerea nemodificata a modalitatilor noastre de productie nu este viabila pe termen lung", a avertizat directorul general al BIT, Juan Somavia, care este prezent pana miercuri la Beijing, pentru a se intalni cu reprezentantii guvernelor, lucratorilor si angajatorilor din aproximativ 12 state din regiunea Asia Pacific.
"Asia inregistreaza progrese fara precedent in ceea ce priveste cresterea si dezvoltarea economica. in acelasi timp insa, fragilitatea ce insoteste cresterea presiunilor ecologice, nesiguranta economica, problemele de guvernare si repartitia inegala a bogatiilor reprezinta o amenintare pentru dezvoltarea continua a regiunii", a adaugat acesta.
Conform studiului BIT, sectorul serviciilor va fi principala sursa de slujbe si va deveni, pana in 2015, principalul sector economic al regiunii, acoperind aproape 41% din sectorul muncii din Asia.
In ceea ce priveste cota din piata muncii acoperita de sectorul industrial, acesta se va ridica de la 23,14% pana la 29,4% pana in 2015. Numarul lucratorilor in sectorul agricol va scadea in aceeasi perioada de la 42,6% pana la 29,4%.
Exodul rural se va intensifica si, drept consecinta, populatia urbana va creste cu 350 milioane persoane pana in 2015, in timp ce populatia din zonele rurale nu va creste decat cu 15 milioane locuitori.
In fiecare an, milioane de lucratori din Asia vor pleca in strainatate pentru a gasi o slujba, estimeaza BIT.
Chiar daca numarul muncitorilor saraci care supravietuiesc cu mai putin de doi dolari pe zi pe persoana s-a redus cu aproximativ 123 milioane incepand cu anul 1996, peste un miliarde locuitori (reprezentand 61,9% din piata muncii din regiune) vor continua sa munceasca in mod informal, cu un nivel redus sau total absent al protectiei sociale, ocupand cel mai des slujbe cu productivitate redusa.
BIT se arata ingrijorat si de poluarea mediului, epuizarea resurselor naturale si modificarile climaterice care ameninta cresterea si dezvoltarea Asiei. in finalul studiului, BIT afirma ca Asia mai este confruntata si cu imbatranirea populatiei - o persoana din zece, sau in anumite state o persoana din patru, va fi in varsta de peste 65 de ani in 2015.
Numarul muncitorilor din Asia va creste cu 200 milioane persoane pana in 2050
Numarul muncitorilor din Asia va creste cu 200 de milioane de persoane pana in 2050, estimeaza un raport publicat de Oficiul International al Muncii (BIT) , prezentat luni la Forumul pentru munca in Asia, organizat de aceasta institutie la Beijing, relateaza AFP.
Te-ar putea interesa si: